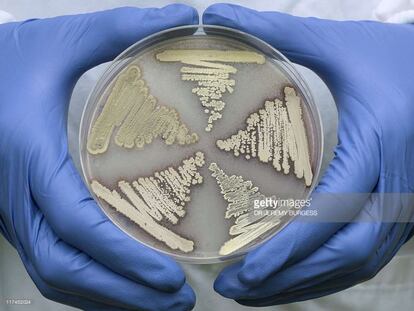

España empastillada
¿Abusamos de los fármacos?

Un país que intenta solucionar todo con pastillas
Un estudio recoge el abuso de ansiolíticos, sedantes y otras medicaciones en España

La victoria de las bacterias
La era de Fleming puede estar tocando a su fin. Y aún no tenemos un buen relevo

“Las farmacéuticas tienen poco interés en desarrollar nuevos antibióticos”
Jesús Rodríguez Baño es el coordinador de la Red Española de Investigación en Patología Infecciosa (REIPI), una organización para luchar contra la resistencia de los microbios
Una mutación global
La resistencia a los antimicrobianos no es sólo un problema de salud, sino también económico. EE UU y Reino Unido han establecido una hoja de ruta para esta crisis

La crisis de los antibióticos en cuatro puntos
La capacidad de adaptación de las bacterias, el mal uso en granjas, la globalización y un problema de mercado hacen peligrar la eficacia de los antimicrobianos

España lidera el abuso de Orfidal y Trankimazin
Una encuesta a 22.000 europeos revela un uso imprudente de medicamentos con receta a espaldas del médico
Productos faciales que le dejarán peor que antes de usarlos
Porque irritan, caducan o no se llevan bien con su piel. Aprenda cómo esquivar los problemas que acarrea la cosmética
Detenido un visitador médico que robaba y estafaba con recetas sustraídas
El arrestado utilizaba los impresos oficiales para comprar en la farmacia de un familiar los medicamentos que él representaba

Espanya lidera l’abús d’Orfidal i Trankimazin
Una enquesta a 22.000 europeus revela un ús imprudent de medicaments amb recepta sense el consentiment del metge

Los fármacos biológicos y sus ‘genéricos’ son igual de buenos
La eficacia, seguridad y calidad de los biosimilares es equivalente a los medicamentos originales

Cooperación internacional, un asunto de vida o muerte
Si queremos evitar la catástrofe en cámara lenta que implica el aumento de la resistencia a los medicamentos, nuestros líderes deben comenzar a actuar ya mismo

En casa del fentanilo, la droga que mató a Prince
El PAÍS comprueba que la letal sustancia, 50 veces más potente que la heroína, se ha extendido por Guerrero, la narcozona más violenta de México

Interior instaura visats per limitar els medicaments dels presos
Institucions Penitenciàries suggereix que els reclusos comprin els seus fàrmacs si el metge li recepta un vetat per Presons

Interior instaura visados para limitar los medicamentos de los presos
Instituciones Penitenciarias sugiere que los reclusos compren sus fármacos si el médico le receta uno vetado por Prisiones

Cómo nos tenemos que cuidar del sol en verano
Desde Mamicenter y a partir de preguntas de varias madres intentaremos aclarar todo o casi todo lo referente a fotoprotectores

'Mindfulness', ¿ciencia o márketing?
La meditación de moda promete controlar la ansiedad y reducir la depresión, pero también tiene un reverso negativo

El paracetamol cura los corazones rotos
El dolor que provoca una ruptura amorosa es real. La manera de aliviarlo, según la ciencia, está en su botiquín

Salud diseña una “estructura de Estado” para fijar el precio de los medicamentos
El Departamento incorpora en el Plan de Salud la creación de la Agencia Catalana del Medicamento

Salut dissenya una “estructura d’estat” per fixar el preu dels medicaments
El Departament incorpora al Pla de Salut la creació de l'Agència Catalana del Medicament

Yo probé la 'Viagra' en crema y esto es lo que pasó
Un periodista experimenta el último remedio con el objetivo de mejorar su vida sexual y la de su pareja. Este es el resultado, paso por paso

Cada vez más homosexuales confían en una pastilla para prevenir el sida
Un español explica cómo consigue la Profilaxis Pre-exposición contra el VIH, que en España aún está en un limbo legal, y con la que prescinde del condón

Una ayuda para dormir bien (y tratar el párkinson)
Cinco cuestiones clave sobre la melatonina, que también afecta al sistema inmune, los problemas inflamatorios y el envejecimiento

¿Qué puedo comer para aliviar el insoportable dolor de la regla?
En la farmacia encontrará algún remedio. Pero el supermercado también es una mina

¿Qué ropa es mejor para ir a la playa si no quiere achicharrarse?
Los tejidos también protegen de las quemaduras solares. Olvide el vestido de lino. Y lleve sombrero siempre

Detenido el jefe narco de Chilapa por el asesinato de tres policías
Un audio revela que el jefe de plaza ordenó la muerte el viernes de los policías federales

La impresión 3D llega a los medicamentos
Esta nueva técnica permitirá la elaboración de fármacos personalizados según las necesidades de cada paciente

Una herramienta para frenar la última amenaza de la malaria
La resistencia del parásito a los fármacos queda confinada de momento al sudéste asiático, según un estudio internacional

Carpetazo a la vieja excusa: el sexo alivia el dolor de cabeza
Remedios avalados por la ciencia que suavizan la cefalea. Aviso: esto no es un catálogo de fármacos

En los campos del opio mexicano
Campesinos pobres plantan amapola en las montañas del Estado de Guerrero, el mayor productor de América bajo el yugo del narco y la persecución del Ejército

Venezuela: vivir en un país sin medicinas
La escasez de fármacos y el bloqueo del Gobierno empuja a muchos pacientes a crear asociaciones para conseguirlos por su cuenta

La mitad de los españoles no sabe para qué sirven los antibióticos
Un Eurobarómetro muestra que España es el país de la UE en el que más crece el uso de estos fármacos
La Policía Municipal retira un juguete de dinosaurio que provoca asfixia
Los artículos, al entrar en contacto con el agua, se expanden y pueden ahogar a los niños
Las heridas no se curan con algodón y Betadine
11 artículos que no pueden faltar en su botiquín de primeros auxilios. Si se ha caído, tire de gasas y desinfectante

Un test para predecir la respuesta a los antidepresivos
La prueba, que mide la inflamación y la relaciona con la reacción a los fármacos, aún es experimental

‘Pequerrecetas’, un menú cinco tenedores
El hospital de Villalba y cuatro importantes chefs se alían para elaborar recetas sencillas y saludables para los más pequeños

Prince murió por sobredosis del opiáceo fentanil
El cantante, un icono de la música pop, falleció a los 57 años el pasado 21 de abril

“El 95% de las medicinas no está disponible en Venezuela”
El presidente de la federación médica denuncia las carencias de productos
Últimas noticias
Maduro sostiene que las agresiones de Estados Unidos son una excusa para la invasión
José Antonio Kast se reúne con Giorgia Meloni para inspirarse en su política migratoria
Aemet confirma que España ha vivido el verano más cálido desde que hay registros
Una erupción del Teide: Tenerife llevará a cabo el primer simulacro de riesgo volcánico de España
Lo más visto
- Ayuso y Almeida se comprometieron a pagar casi 400.000 euros para promocionar Madrid en la etapa final de la Vuelta que acabó suspendida
- Qatar reúne a más de 50 países árabes e islámicos para trazar una respuesta diplomática común al ataque israelí en Doha
- Última etapa de la Vuelta a España| El Gobierno cifra en 100.000 los manifestantes en las protestas propalestinas
- Javier Bardem, con un pañuelo palestino en los Emmy: “Hay que denunciar lo urgente, el genocidio de Israel en Gaza”
- Los impulsores de las protestas propalestinas: “Nuestro objetivo era conseguir una movilización masiva”